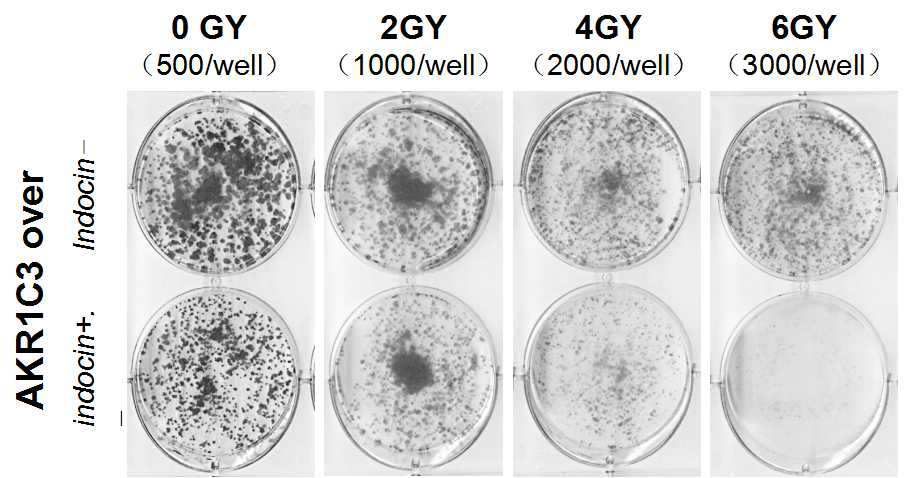

Corrections:
Correction: Overexpression of AKR1C3 significantly enhances human prostate cancer cells resistance to radiation
Metrics: PDF 1874 views | ?
1 Department of Radiation Oncology, Peking University First Hospital, Peking University, Beijing, China
2 State Key Laboratory of Natural and Biomimetic Drugs, School of Pharmaceutical Sciences, Peking University, Beijing, China
3 Department of Radiation Oncology, Jiangsu Cancer Hospital Affiliated with Nanjing Medical University, Nanjing, China
4 Tangshan People’s Hospital, Hebei, China
5 Beijing Reciproca Pharmaceutical Co. Ltd., Beijing, China
* These authors contributed equally to this work
Published: April 28, 2020
This article has been corrected: In Figure 2C, in the column labeled ‘4GY’, the picture of Indocin- is mistakenly identical to the picture for Indocin+. The corrected Figure 2C, obtained using original data, is shown below. The authors declare that these corrections do not change the results or conclusions of this paper.
Original article: Oncotarget. 2016; 7:48050–48058. DOI: https://doi.org/10.18632/oncotarget.10347.
Figure 2: Indomethacin, an inhibitor of AKR1C3 activity, overcomes radiation resistance. (A) AKR1C3-over cells and control cells were treated with or without 20 mmol/ indomethacin for 2 days, and western blotting was performed; (B, C) AKR1C3-over cells and Control cells were treated with or without 20 mmol/ indomethacin for 2 days, and clonogenic assay was performed; (D) Colony forming efficiency were calculated and results are presented as means SD of two experiments performed in duplicate.
 All site content, except where otherwise noted, is licensed under a Creative Commons Attribution 4.0 License.
All site content, except where otherwise noted, is licensed under a Creative Commons Attribution 4.0 License.
PII: 27542
